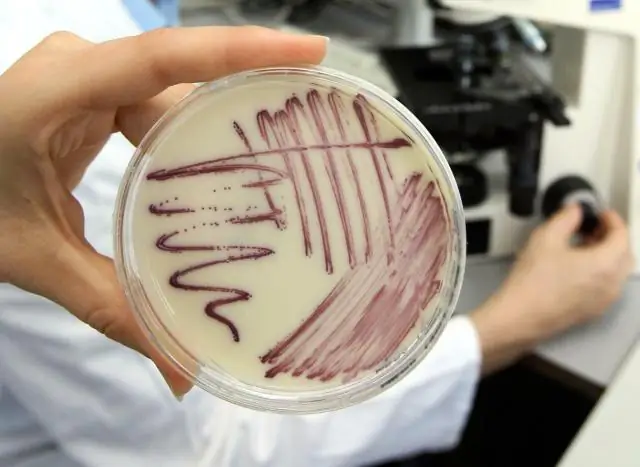
Открытие циркадных часов может помочь повысить эффективность использования воды на пищевых предприятиях

Открытие ученых Texas A&M AgriLife Research в Далласе дает новое представление о биологических или циркадных часах, о том, как они регулируют высокую эффективность использования воды некоторыми растениями и как другие, включая пищевые растения, могут быть улучшены для с той же эффективностью, возможно, расти в непригодных для них сегодня условиях.
Ученые в своем исследовании, опубликованном в журнале Genome Biology and Evolution, идентифицировали 1 398 факторов транскрипции, белков, которые регулируют экспрессию определенных генов в ананасе. Из них почти половина демонстрировала специфичные для времени суток или суточные паттерны экспрессии генов, которые могут быть важны для выявления генетических механизмов контроля использования воды растениями.
«Это важный шаг в понимании общей циркадной регуляции водосберегающего фотосинтеза и того, как эта эффективность может быть воспроизведена в других растениях, а именно в пищевых культурах», - сказал д-р Цинъи Ю, доцент отдела исследований растений AgriLife Research. геномики в Далласе.
Исследование ее команды последовало за Нобелевской премией по физиологии и медицине 2017 года, присужденной в этом году за открытия, связанные с молекулярными механизмами, контролирующими циркадный ритм.
Группа Ю сосредоточилась на ананасе, водосберегающем тропическом растении, которое использует метаболизм крассуловой кислоты или фотосинтез САМ. Во время фотосинтеза растения САМ открывают свои устьица ночью, чтобы облегчить водосберегающий газообмен по сравнению с растениями С3, чей газообмен с меньшим водосбережением происходит днем. Большинство продовольственных культур, включая рис, пшеницу, сою и хлопок, используют фотосинтез C3.
Исследователи обнаружили, что определенные гены, регулируемые биологическими часами, одинаково экспрессируются в двух типах тканей растения ананас: в тех, которые участвуют в фотосинтезе, и в тех, которые не участвуют. По словам Ю, это открытие представляет собой новую парадигму для идентификации основных часовых генов. Метод выявил, что может быть компонентами циркадных часов или генератора, регулирующего активность САМ.
Открытие является прорывом в понимании генетических механизмов высокоэффективного фотосинтеза CAM и использовании этих знаний для выращивания сельскохозяйственных культур в будущем, сказал Ю.
«Мы считаем, что в какой-то момент мы сможем улучшить водоемкие растения C3 до такой степени, что они также будут использовать фотосинтез CAM», - сказала она. «Понимая этот генетический контроль, мы можем помочь растениям адаптироваться к изменяющемуся климату, возможно, выращивая пищу в условиях, которые сегодня были бы невозможны."
Ю сказал, что следующим шагом в текущем исследовании является подтверждение функций предполагаемого циркадного осциллятора.